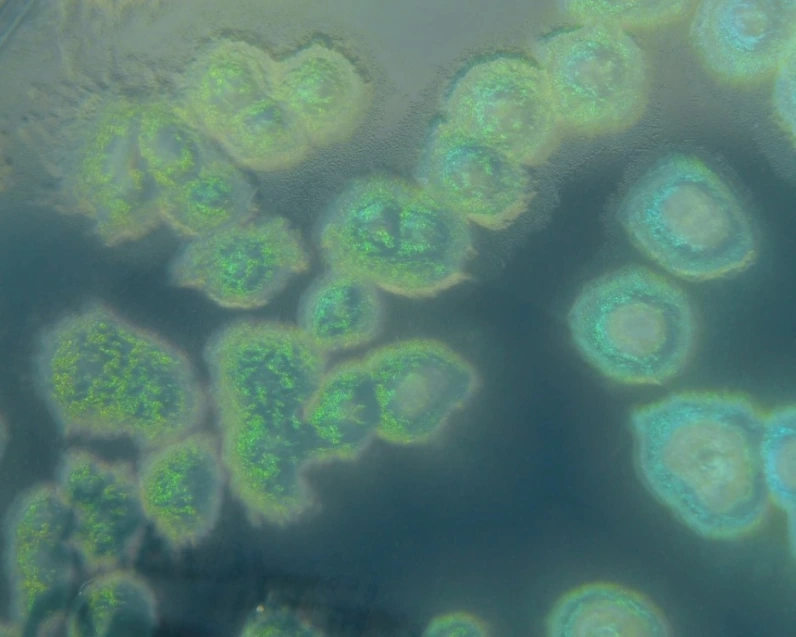
녹농균-위키커먼스.PNG

최시원 프렌치불독, 녹농균 DNA가 과실치사죄 열쇠
녹농균 DNA가 과실치사죄 열쇠.. 개는 안락사 될 수도
뉴스 읽어주는 김평호 변호사입니다.
지난달 30일 최시원(31) 씨가 기르는 프렌치불독이 한일관 대표를 물었고, 피해자는 통원치료를 받은 6일 후 패혈증으로 사망하는 사건이 발생하였습니다. 유가족들은 최시원 씨 측과 합의하였다고 전해지고 있습니다. 삼가 고인의 명복을 빕니다.
관련기사: 녹농균 '최시원 프렌치불독 사고' 한일관 대표 사인, 처벌은?
이번 사건으로 최시원 씨가 어떤 처벌을 받게 될지, 최시원 씨의 프렌치불독 개를 안락사 시키게 되는지 관심을 모으고 있습니다(정확히는 개의 소유자인 최시원 씨가 아니라 당시 개를 돌보고 있던 최시원 씨의 아버지가 처벌을 받을 수 있습니다).
과실치상? 과실치사?
이번 사건은 피해자가 사망하는 결과가 발생하였기 때문에 형법상 과실치사죄가 문제 됩니다. 그러나 개가 문 것과 사망 사이에 인과관계가 없다면 사망의 책임까지 물을 수는 없기 때문에 과실치상죄만 성립할 수 있습니다. 과실치상죄는 피해자가 처벌을 원하지 않을 경우 강제수사나 처벌을 할 수 없습니다. 결국 사건의 핵심은 개가 문 것과 피해자 사망 사이의 '인과관계'가 있는지입니다.
사망진단서 사망원인: 패혈증
혈액검사 결과: 녹농균 검출
 녹농균, 출처: 위키커먼스
녹농균, 출처: 위키커먼스이번 사건의 경우 사망진단서상 사망원인이 패혈증으로 기재되어 있고 혈액 검사 결과 녹농균이 검출되었습니다. 이러한 점들을 보면 피해자의 사망 원인은 녹농균 감염에 의한 패혈증으로 보입니다. 녹농균은 피해자의 집에 있었을 수도, 병원에 있었을 수도, 프렌치불독의 입이나 혈액에 있었을 수도 있는데요, 이 '녹농균'이 어떻게 피해자에게 감염되었는지가 인과관계 유무의 핵심 열쇠가 될 것으로 보입니다.
사망 원인을 분석하려면 프렌치불독에서 '녹농균' 검출되는지 조사해야
먼저, 최시원 씨의 프렌치불독의 입과 혈액을 검사하여 '녹농균'이 검출되는지 확인할 필요가 있습니다(경찰은 사망진단서상 사망원인이 패혈증이어서 개가 문 것과 관련이 없고, 피해자 유족이 고소를 하지 않아 수사를 하지 않는다고 밝히고 있습니다. 그러나 과실치사죄는 피해자의 처벌 의사와는 무관하게 수사가 가능한 범죄로 경찰의 의지에 따라 수사가 가능합니다).
다음, 피해자의 혈액에서 검출된 녹농균과 프렌치불독의 녹농균이 같은 것인지 균의 유전자 검사 등의 방법으로 확인이 필요합니다.
검사 결과 프렌치불독에서 녹농균이 검출되지 않거나, 검출되더라도 같은 녹농균이라고 볼 수 있다는 결과가 나오지 않을 경우 '인과관계'는 부정되고 과실치사죄를 물을 수 없을 것으로 보입니다.
검사 결과 프렌치불독의 녹농균과 피해자 혈액에서 나온 녹농균이 같은 균이라고 하더라도, 최시원 씨가 '개가 사람에게 치명적일 수 있는 균을 보유하고 있었다'는 사실을 미리 알고 있었던 사실이 밝혀지지 않는 이상 예측 가능성이 없어 역시 과실치사죄를 묻기는 어려워 보입니다.
결국 유족들이 합의한 이상 동물보호법상 외출시 반려견에게 목줄을 채울 의무를 위반한 것으로 5만 원 내지 10만 원 사이의 과태료를 부과 받는데 그칠 것으로 보입니다(프렌치불독은 동물보호법상 '맹견'이 아님).
개는 안락사 되나?
프렌치불독, 출처: 픽사베이
프렌치불독, 출처: 픽사베이현행법상 최시원 씨 개의 소유권을 피해자 측에 강제로 넘기게 할 방법은 없습니다.
다만, 과실치상죄 또는 과실치사죄로 처벌을 받는 경우 최시원 씨의 개는 '범죄행위에 제공한 물건'이 되어 몰수의 대상이 됩니다.
형법 제48조(몰수의 대상과 추징) ①범인이외의 자의 소유에 속하지 아니하거나 범죄후 범인이외의 자가 정을 알면서 취득한 다음 기재의 물건은 전부 또는 일부를 몰수할 수 있다.
1. 범죄행위에 제공하였거나 제공하려고 한 물건
검사는 몰수물이 유가물일 경우에는 공매에 의하여 국고납입 처분을 하여야 합니다(검찰압수물사무규칙 제28조 제1항). 그러나 검사는 특히 필요하다고 인정할 때에는 몰수물에 관하여 상당한 처분을 할 수 있습니다(검찰압수물사무규칙 제36조 제1항).
최시원 씨 프렌치불독의 균이 피해자를 사망에 이르게 한 것이 밝혀져 몰수된다면 이 프렌치불독은 더 이상 유가물이라고 보기 어려워 검사가 프렌치불독에 관하여 안락사 시키는 것이 가능할 것으로 보입니다.
오늘은 최시원씨의 프렌치불독 사건 뉴스를 통하여 과실치상죄, 과실치사죄 그리고 형법상 몰수에 관하여 알아보았습니다.
내일 뵙겠습니다.
[면책 공고]
이 글은 일반적인 정보를 제공하기 위한 것이고 법률적인 자문을 제공하기 위한 것이 아닙니다.
이 글에서 취득한 정보로 인해 문제가 발생하여 직·간접적으로 손해를 입었다 하더라도 여해법률사무소는 어떠한 법적 책임도 지지 아니하며, 이 글에서 제공하는 정보에 기반하여 조치를 취하시기에 앞서 반드시 저희 사무소에 법률적 자문을 구하시기 바랍니다.